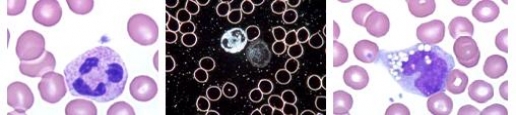
neutrophil-in-bright-field
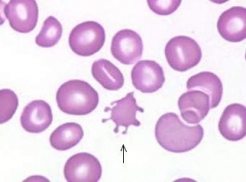
acanthocytes-in-bright-field
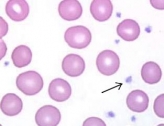
platelet
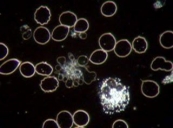
platelet-aggregation-in-darkfield
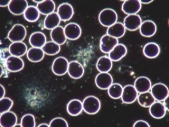
platelet-aggregation-in-darkfield-01

Biggest disadvantage of Live Blood Analysis in Dark Field is the fact it is based on observations and interpretations with no general scientific acceptance. Anybody with possibilities of self-publication has therefore the chance to voice his own interpretations. Thus was the situation over 50 years ago already and it will never change.
However, practitioners doing Live Blood Analysis should at least be able to identify blood parts correctly, which are also seen by hematologists in stained bright field samples. This is a must in order to gain any form of credibility of Live Blood Analysis in Dark Field.
Red Blood Cells / Erythrocytes
Erythrocytes are not always the same in form and size. This is visible in stained bright field as well as in live blood dark field samples. Therefore scientifically acknowledged terminology exists for these cells seen in blood.
Example: Acanthocytes
Acanthocytes are red blood cells with irregularly spaced projections. These projections vary in width but usually have a rounded end. They may be found in chronic liver and other diseases.
![]() |
![]() |
|---|---|
| Acanthocytes in bright field | Acanthocytes in dark field |
Anisocytosis, Acanthocytes, Echinocytes, Elliptocytes, Poikilocytes, Reticulocytes, Schistocytes, Stomatocytes, Dakrocytes and Target Cells are hematological terms, which live blood analysts need to know and they should be able to identify those in dark field.
Rouleaux / Coin roll formation
Coin roll formation in dark field is nowadays world-wide abused by sellers of remedies and gadgets to demonstrate bad blood circulation. An absolute favorite is a dark field picture with coin rolls titled “before” and a normal dark field picture titled “after”. Worst of it all, in most cases it’s not even real rouleaux but simply blood sludge like in the “before” picture below.
![]() |
![]() |
|---|---|
| “before” | “after” |
According to the “Oxford Textbook of Medicine” real rouleaux in a blood sample resembles the visual analogue of a high ESR (erythrocyte sedimentation rate). It is therefore a non-specific indicator of disease.
White Blood Cells / Leucocytes
There are 5 different forms of white blood cells, Neutrophil, Eosinophil and Basophil Granulocytes as well as Monocytes and Lymphocytes. Lymphocytes are divided into B- and T-Lymphocytes and Natural Killer cells (NK).
Again, dark field analysts should be able to classify them correctly.
Example: Neutrophil Granulocyte and Monocyte
| Neutrophil in bright field | Neutro & Mono in dark field | Monocyte in bright field |
Thrombocytes / Platelets
Platelets are also visible in stained bright field samples. However, Platelet aggregations are only visible in untreated blood smears. The different staining methods separate the Platelet aggregations.
Platelets in stained sample
![]() |
![]() |
![]() |
|---|---|---|
| Platelet aggregation in untreated blood smear | Platelets in stained sample | in dark field |
Platelet aggregation, often entangled with fibrin, is frequently observed in dark field. No surprises here – Cardio-vascular diseases are the most prevalent ones these days in the western world. Millions of people world-wide are on Aspirin. It blocks the formation of thromboxane A2 in platelets, producing an inhibitory effect on platelet aggregation. However, rebound effects after cessation have been shown in several studies.
It is amazing how many dark field analysts world-wide diagnose these platelet aggregations as “Candida”. People with systemic candida infections are very ill and usually need treatment in an intensive care unit. They are hardly able to see a physician for live blood analysis in dark field.
Candida needs an acidic environment for existence (e.g. vagina pH2).
![]() |
![]() |
![]() |
|---|
Examples of platelet aggregations in dark field
Normal blood plasma pH is 7.38 – 7.42. If this pH drops below 7.36 metabolic acidosis is imminent.
There are 3 mechanisms for the body to regulate the blood plasma pH:
- Physiological buffer mechanism
- Kidney excretion
- Acid dump in tissues in exchange for alkaline minerals
Even the blood drop of a cancer patient at the time of sampling has a pH of 7.36 or above. Erythrocytes transport oxygen but don’t use it. They have an anaerobic cell metabolism with an end product of lactic acid. Mucor racemosus also produces lactate. Aspergillus niger produces citric and oxalic acids. This leads to a gradual left shift of the pH of live blood samples and allows the pathological developments as described by Professor Enderlein.
Conclusion: The unhealthier a person the quicker the pathological developments.
Interpretation and naming of the pathological developments in live blood samples is a free for all for dark field analysts and frowned upon by Hematologists. However, the credibility of live blood analysis in dark field suffers the most when practitioners are unable to identify blood particles correctly, which can also be seen by Hematologists.
Live Blood Analysis Dark Field Microscopy explained
OMAX 40X-2500X USB3 10MP Digital Darkfield Lab Siedentopf Trinocular LED Microscope for Live Blood